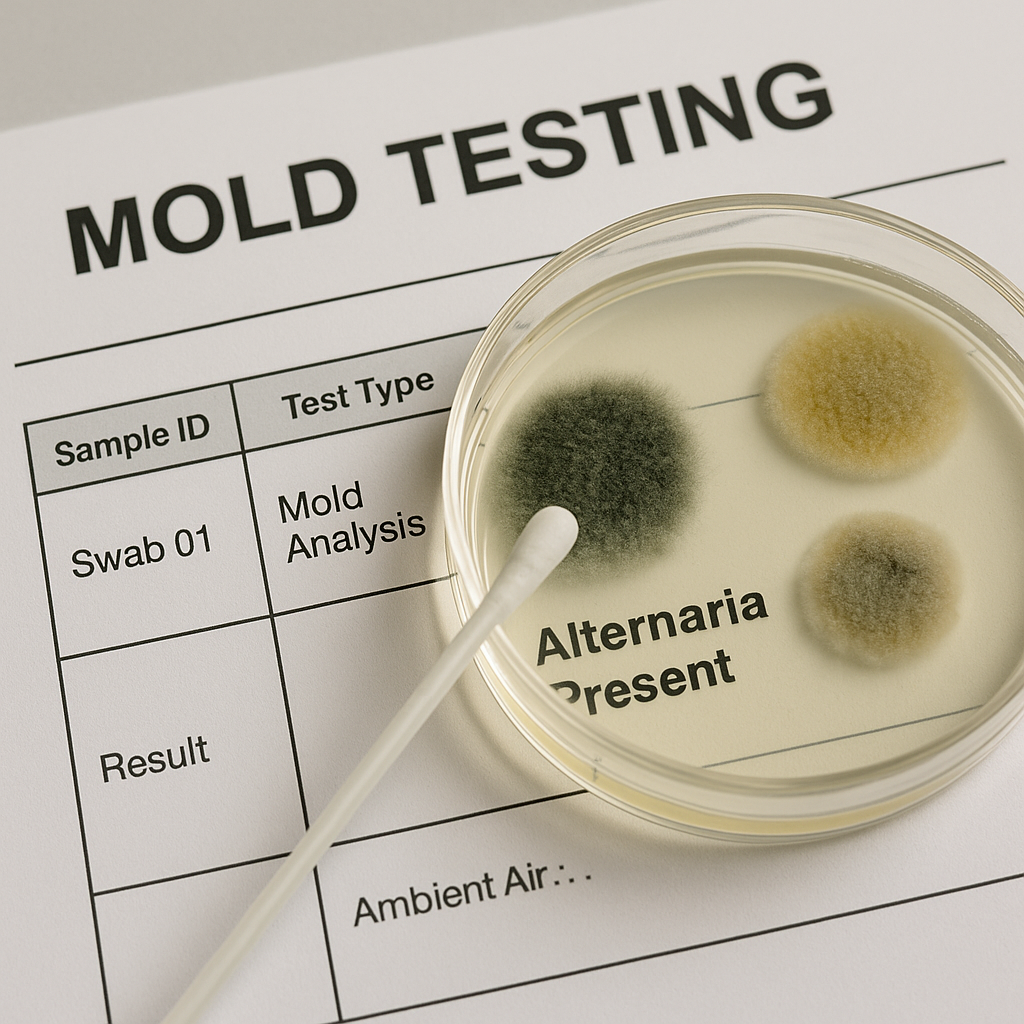
Reviewing lab mold report at desk

Certified Mold Inspection & Testing



Post-Flood Mold Inspection that’s fast, thorough & insurance-ready
We help homeowners, property managers, and contractors detect moisture and mold growth after floods or leaks. Get same-day scheduling and detailed, lab-backed reports you can use for claims and remediation.
Certified Inspectors
Thermal imaging, hygrometers, and air/surface sampling when needed.
Fast Scheduling
Flexible, same-day/next-day appointments with digital reports.
Insurance-Ready
Clear documentation that adjusters and remediators understand.